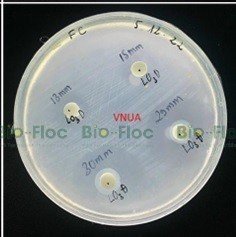
bệnh trắng da

Contents
1. Bệnh trắng da, bạc mang, trắng đuôi trên cá và mối nguy cho người nuôi cá
Vi khuẩn Flavobacterium columnare là loại vi khuẩn đang gây thiệt hại nặng nề cho người nuôi cá miền bắc. Loài vi khuẩn này được dự báo sẽ bùng nổ và gây thiệt hại hơn nữa trong thời gian tới. Các loài cá nuôi như cá Hồi Vân, cá Nheo Mỹ, cá Tra, cá Rô Phi, cá Trắm Cỏ, cá Trắm Đen, cá Chạch….đều là đối tượng tấn công của vi khuẩn F. columnare. Đặc biệt loài vi khuẩn này gây ảnh hưởng nghiêm trọng trên cá nước ngọt nuôi với tỷ lệ chết 80 – 100% cá hương, cá giống và 35 – 60% cá trưởng thành (từ Thanh Dung & cs 2012). Bệnh do vi khuẩn F. columnare có đặc trưng là tia mang xơ, bạc trắng, xơ vây, xuất hiện các đốm bạc màu trên da. Gần đây, các hộ nuôi tại Hải Dương, Hà Nội, Nam Định đang bị thiệt hại nặng từ nhóm bệnh này. Theo các chuyên gia, nhóm bệnh này sẽ thật sự đáng ngại trong những năm tới với người chăn nuôi.

Hình 1. Dấu hiệu lâm sàng trên cá rô phi nhiễm F. columnare. (A, B, C) Mẫu cá thu từ hệ thống nuôi; (D, E, F) Mẫu cá cảm nhiễm. Cá nhiễm bệnh có dấu hiệu xơ, bạc hoặc xám vàng tia mang (mũi tên đỏ) và bạc da, xơ tia vây (mũi tên vàng). ảnh PGS. TS. Trương Đình Hoài – Nhóm NCM Bệnh Thủy sản.

Hình 2: hình ảnh triệu chứng lâm sàng trên cá trắm cỏ nhiễm F. columnare. ảnh PGS. TS. Trương Đình Hoài – Nhóm NCM Bệnh Thủy sản.
Máy phát điện công nghiệp chính hãng – 100% nhập khẩu.
Máy phát điện 630kVA – Lựa chọn hoàn hảo cho ngành công nghiệp.
2. Nghiên cứu về khả năng đối kháng với vi khuẩn Flavobacterium columnare của chủng vi sinh Lactobacillus plantarum – L03
Cuối năm 2022, công ty TNHH Bio-Floc có kết hợp với phòng nghiên cứu bệnh học thuỷ sản – Khoa Thuỷ Sản – Học Viện Nông Nghiệp Việt Nam triển khai thí nghiệm đánh giá khả năng kháng khuẩn của các chủng vi sinh vật có lợi sản xuất tại Bio-Floc với các vi khuẩn gây bênh trên đối tượng thuỷ sản, trong đó có vi khuẩn gây bệnh F.columnare.
Hình 3. Kết quả khả năng kháng khuẩn các chủng Lactobacillus plantarum – L03 với vi khuẩn F.columnare
Kết quả cho thấy với sinh khối của Lactobacillus plantarum – L03 đã tạo ra vòng kháng khuẩn từ 29 mm tới 30 mm, đây là vòng kháng khuẩn rất lớn. Với vòng kháng khuẩn như vậy thể hiện rất rõ khả năng ức chế vi khuẩn F.columnare gây ra bệnh trắng da, bạc mang, trắng đuôi trên cá của Lactobacillus plantarum – L03. Điều này mở ra hướng khống chế nhóm bệnh nguy hiểm này bằng phương pháp sinh học là rất cao.
Hiện tại các chế phẩm Bio-Floc đã được tích hợp với hàm lượng rất cao chủng vi khuẩn Lactobacillus plantarum – L03 vào trong các sản phẩm xử lý môi trường như Bio-Floc EM Gốc, Bio-Floc 02, EM AQUA, BFC 02 pro và sản phẩm men vi sinh sống PP Floc EM, Lactoprobi giúp bà con nuôi cá phòng và khống chế dịch bệnh do F.columnare gây ra. Bà con nuôi cá hãy liên hệ với nhân viên Bio-Floc hoặc hệ thống bán hàng của Bio-Floc gần nhất hoặc liên hệ hotline của công ty 0828998686 để được tư vấn cụ thể.
𝐂𝐨̂𝐧𝐠 𝐭𝐲 𝐓𝐍𝐇𝐇 𝐁𝐢𝐨-𝐅𝐥𝐨𝐜
- Địa chỉ: Cụm CN Liên Hiệp – Phúc Thọ – Hà Nội
- Web: http://biofloc.vn/
- Hotline: 𝟎𝟖𝟐𝟖. 𝟗𝟗. 𝟖𝟔𝟖𝟔
- Email: biofloccompany@gmail.com
- OA Zalo: BioFloc trên Zalo



